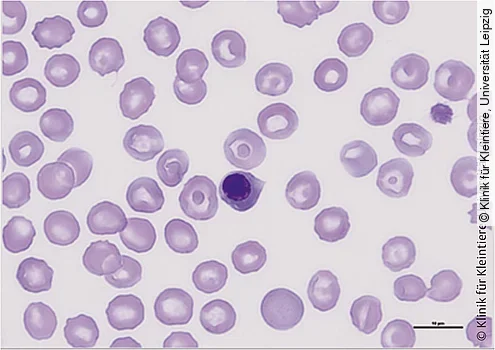

Nach der ersten Einschätzung des Patienten und ggf. lebensrettenden Maßnahmen sollten Blutuntersuchungen eingeleitet werden. Hierzu gehören ein vollständiges Blutbild sowie ein Blutausstrich, umfangreiche blutchemische Untersuchungen, eine Blutgasuntersuchung und die Blutgerinnung. Außerdem können eine Harnuntersuchung mit Sediment und Röntgenaufnahmen vom Thorax wichtige Hinweise liefern [10].
Blutbild
Durch die Hitzeeinwirkung kann es im Zuge einer akuten Aktivierung der Entzündungskaskade zur Leukozytose kommen, aber auch eine Leukopenie kann infolge eines bereits fortgeschrittenen septischen Geschehens vorliegen. Bei Hinweisen auf eine Anämie können subkutane oder gastrointestinale Blutungen infolge von Gerinnungsstörungen ursächlich sein.
Entsprechend einer Studie von 2006 entwickelten 83 % der untersuchten Hunde eine Thrombozytopenie , die die Autoren auf einen erhöhten Verbrauch infolge einer Vaskulitis, gastrointestinaler Blutungen und einer hitzebedingten Thrombozytenaggregation zurückführten [[5]]. Neuere Untersuchungen geben allerdings Hinweise darauf, dass die Thrombozytopenie bei Hitzschlagpatienten autoimmun durch die Bildung antithrombozytärer Antikörper vermittelt ist [19].
Blutausstrich
Im Blutausstrich werden häufig kernhaltige Erythrozyten nachgewiesen (nRBC, (Abb. 1)). Im Gegensatz zum Menschen ist dies eine Besonderheit beim Hund und wird wahrscheinlich durch direkte thermische Zytotoxizität im Knochenmark hervorgerufen. Ferner korreliert die Menge der nRBC mit der Rate an sekundären Komplikationen und kann als prognostischer Faktor hinzugezogen werden. Die Autoren dieser Studie geben unterschiedliche Cut-Off-Points an, je nachdem, welche Sensitivität oder Spezifität von Interesse ist [1].
Im Blutausstrich können zudem auch Schistozyten (bestätigen Anzeichen einer DIC) und botryoide Kernformationen der Leukozyten (charakteristisch für Hitzeschock-Patienten) gefunden werden [10], [13].
Blutchemie
Erhöhungen von Alaninaminotransferase (ALAT ), alkalischer Phosphatase (AP ), Bilirubin, Harnstoff, Kreatinin und Kreatinkinase (CK ) sind zu erwarten. Dies kann i. d. R. auf direkte thermisch-zytotoxische Effekte in sämtlichen Organsystemen zurückgeführt werden, wobei mögliche Differenzialdiagnosen dennoch berücksichtigt werden sollten [10]. Des Weiteren spielt die Hypoglykämie eine wichtige Rolle, die durch Sepsis, Leberschädigung, Anfallsgeschehen oder eine unverwandte Grunderkrankung bedingt sein kann [10].
Die Serum-Troponin-I-Konzentration kann infolge thermischer Schädigung des Myokards ebenfalls erhöht sein [14].
Säure-Basen-Status
Oftmals kommt es zu einer metabolischen Azidose , verbunden mit einer kompensatorischen respiratorischen Alkalose und Verschiebungen im Elektrolythaushalt. Unter anderem kann eine Hyperkaliämie infolge eines massiven Zelluntergangs mit Rhabdomyolyse auftreten [10].
Harnuntersuchung
Da das Nierenparenchym bei Hitzeeinwirkung sehr oft massiv in Mitleidenschaft gezogen wird, sollte unbedingt eine ausführliche Harnuntersuchung inklusive Sediment eingeleitet werden. Auf diese Weise lässt sich ein akutes Nierenversagen frühzeitig erkennen und therapieren. Die Harnproduktion muss gemessen werden [10], [15].
Blutgerinnungsparameter
Da Hitzschlagpatienten ein hohes Risiko für eine disseminierte intravasale Gerinnung (DIC) besitzen, sollten in jedem Fall Gerinnungsparameter bestimmt werden. Dazu gehören aPTT, PT, Schleimhautblutungszeit und Thrombozytenzahl [10]. Als Fibrin-Spaltprodukte können D-Dimere nachgewiesen werden [18].
Weitere Diagnostik
Thoraxröntgenaufnahmen sind in jedem Fall angezeigt, wenn der Patient auffällige Auskultationsbefunde aufweist. In einer Untersuchung von 2015 wird von einem Hund berichtet, der ca. 1 Woche nach einem diagnostizierten Hitzschlag eine nekrotisierende Pneumonie mit beidseitigem spontanen Pneumothorax entwickelte [8]. Insbesondere bei geriatrischen Patienten lassen sich u. U. zusätzliche Informationen durch Herz- und Abdomenultraschall und ggf. MRT gewinnen [10].
Der Originalartikel ist erschienen in:
(RG)
1 Aroch I, Segev G, Loeb E. et al. Peripheral nucleated red blood cells as a prognostic indicator in heatstroke in dogs. J Vet Intern Med 2009; 23: 544-551
2 Bouchama A, Knochel JP. Heat stroke. N Engl J Med 2002; 346: 1978-1988
3 Bruchim Y, Segev G, Kelmer E. et al. Hospitalized dogs recovery from naturally occurring heatstroke; does serum heat shock protein 72 can provide prognostic biomarker?. Cell Stress Chaperones 2016; 21 (1): 123-130
4 Bruchim Y, Loeb E, Saragusty J. et al. Pathological findings in dogs with fatal heatstroke. J Comp Path 2009; 140: 97-104
5 Bruchim Y, Klement E, Saragusty J. et al. Heat stroke in dogs: A retrospective study of 54 cases (1999–2004) and analysis of risk factors for death. J Vet Intern Med 2006; 20: 38-46
6 Cunningham JG, Klein BG. Textbook of Veterinary Physiology. 4th ed. St. Louis: Saunders Elsevier; 2007
7 Engelhardt W. Physiologie der Haustiere. 5. Aufl. Stuttgart: Enke; 2015
8 Garber JB, Saile K, Rademacher N. et al. Pneumothorax in a dog caused by necrotizing pneumonia secondary to heatstroke. J Vet Emerg Crit Care (San Antonio) 2015; 25 (6): 759-764
9 Gordon LE. Hyperthermia and heatstroke in the canine. Im Internet: http://usarveterinarygroup.org/usarvet/hyperthermia-heatstroke-k9/ (Zugriff: ) Stand: 12.01.2017
10 Hemmelgarn C, Gannon K. Heatstroke: thermoregulation, pathophysiology and predisposing factors. Comp Contin Educ Vet 2013; 35 (7): E4
11 Hemmelgarn C, Gannon K. Heatstroke: clinical signs, diagnosis, treatment and prognosis. Comp Contin Educ Vet 2013; 35 (7): E3
12 Johnson SI, McMichael M, White G. Heatstroke in small animal medicine: a clinical practice review. J Vet Emerg Crit Care 2006; 16 (2): 112-119
13 Mastrorilli C, Welles EG, Hux B. et al. Botryoid nuclei in the peripheral blood of a dog with heatstroke. Vet Clin Pathol 2013; 42: 145-149
14 Mellor PJ, Mellanby RJ, Baines EA. et al. High serum troponin I concentration as a marker of severe myocardial damage in a case of suspected exertional heatstroke in a dog. J Vet Cardiol 2006; 8 (1): 55-62
15 Powell LL. Canine heatstroke. NAVC clinician’s brief 2008; 13-16
16 Segev G, Aroch I, Savoray M. et al. A novel severity scoring system for dogs with heatstroke. J Vet Emerg Crit Care (San Antonio) 2015; 25 (2): 240-247
17 Silverstein DC, Hopper K. Small Animal Critical Care Medicine. St. Louis, Missouri: Saunders Elsevier; 2009
18 Teichmann S, Turkovic V, Dörfelt R. Hitzschlag bei Hunden in Süddeutschland – Eine retrospektive Studie über 5,5 Jahre. Tierarztl Prax K 2014; 42: 213-222
19 Zenker I, Keller L, Meichner K. et al. Immune mediated destruction of platelets in dogs with heat stroke: A prospective study. Tierarztl Prax K 2009; 37: 314-318






